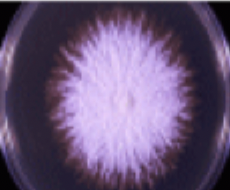
<p>cottony/velvety/granular texture with a range of pigments</p>

1/43
Year 1 - Semester 1
Name | Mastery | Learn | Test | Matching | Spaced | Call with Kai |
|---|
No study sessions yet.
which is the largest fungal phylum?
ascomycota
general features of fungi
eukaryotic, highly developed cellular structure, aerobes, some strict aerobes with optimum temp of 20-30 degrees, non-photosynthetic (lack chlorophyll), absorb nutrients from their environment, resistant to antibacterial drugs, unicellular or multicellular, rigid cell walls make them non-motile, reproduce sexually or asexually via spores
3 main morphological forms of of fungi
yeast, mould and dimorphic
dimorphic fungi
fungi that is both yeast- and mould-like
macroscopic appearance of fungal yeast
pasty colonies that resemble bacteria

microscopic appearance of fungal yeast
large oval/round cells that reproduce by budding

macroscopic appearance of fungal mould
cottony/velvety/granular texture with a range of pigments
microscopic appearance of fungal mould
branching, thread-like filaments called hyphae form a tangled mass called mycelium

hyphae
multicellular filaments of fungi which form myceliums together, they grow radially at the tips of fungi and form branches
2 types of fungal spores
sexual and asexual
function of fungal spores
to allow asexual and sexual reproduction to occur
main components of fungal plasma membranes
chitin and ergosterol
examples of anti-fungal agents
polyenes, azoles, allylamines, echinocandins, griseofulvin
how do polyenes work?
they bind to ergosterol and disrupt fungal cell membranes
how do azoles work?
they interrupt enzymatic synthesis of ergosterol
how do allylamines work?
they inhibit fungal squalene which is a key precursor to ergosterol
how do echinocandins work?
they disrupt fungal cell glucan synthesis which causes cell lysis
how does griseofulvin work?
it inhibits mitosis of fungal cells
positive effects of fungal metabolites
plant growth regulators, pigments/dyes, used in cheese making, microbial enzymes, anticancer, health benefits, antibiotics
negative effects of fungal metabolites
plant diseases, mycotoxins, food spoilers
main mechanisms for the spread of fungal diseases
tissue invasion, toxin production, induction of hypersensitivity
dermatophytes
fungal organisms that require keratin for growth so embed in keratinised layers of the skin, nails or hair, causing superficial mycosis which classically presents as ring worm lesions
histological appearance of microsporum dermatophytes
boat shaped macroconidia, no microconidia

histological appearance of trichophyton dermatophytes
lots of microconidia, cigar-shaped macroconidia

mycotoxins
metabolites of certain fungal species which are produced when toxigenic species grow on crop, pasture or stored feed
mycotoxicosis
ingestion of food contaminated with mycotoxins
2 main types of asexual fungi spores
sporangiospores and conidia
importance of fungal spores
allows identification of fungi, able to reestablish an entire mycelium, spread fungi in the environment
uses of fungi
biodegradation, industrial fermentation processes, source of protein-rich food products, bioremediation, symbiotic relationships with plants used in agriculture, biological control of pests, production of antibiotics
3 main types of mycotic/fungal disease
true mycosis, mycotoxicoses, hypersensitivity
true mycosis
when fungi invade tissue causing a host response
mycotoxicoses
when animals are poisoned by food products contaminated by fungi which produce toxins
fungal hypersensitivity
an allergic reaction to fungal moulds and spores
where does superficial/cutaneous mycosis occur?
hair, skin or nails
where does subcutaneous mycosis occur?
dermis or subcutis
where does systemic mycosis occur?
internal organs
types of dermatophytes
geophilic (soil associated), zoophilic (animal associated), anthropophilic (human associated)
factors that make patients more susceptible to fungal infections
prolonged antibiotic therapy, underlying disease, breakdown of mucocutaneous barrier (usually through trauma), immunosuppression, exposure to heavy load of fungal spores
opportunistic mycosis
fungal infection which occurs almost exclusively in patients whose normal defence mechanisms are impaired, caused by fungi which have a very low inherent virulence
main effects of mycotoxins
immunosuppression, developmental defects caused by exposure during pregnancy, carcinogenesis, accumulation in tissues of food producing animals causes human exposure
aflatoxicosis
poisoning from aflatoxins produced by Aspergillus fungi, toxins mainly target the liver
ergotism
a poisoning from ergot fungus that can cause gangrenous or convulsive symptoms due to contaminated grains like rye